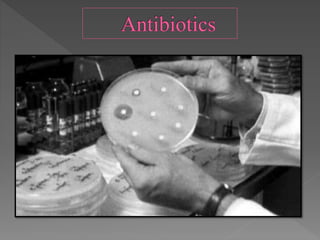

Microbes are ubiquitous and diverse organisms that play vital roles in various processes, including fermentation for food production, antibiotic development, and wastewater treatment. They contribute to the creation of products like curd, alcohol, and organic acids, while also being essential in sewage treatment through aerobic and anaerobic processes. Additionally, biocontrol methods using microbes are emerging to manage pests in agriculture, promoting sustainable practices.